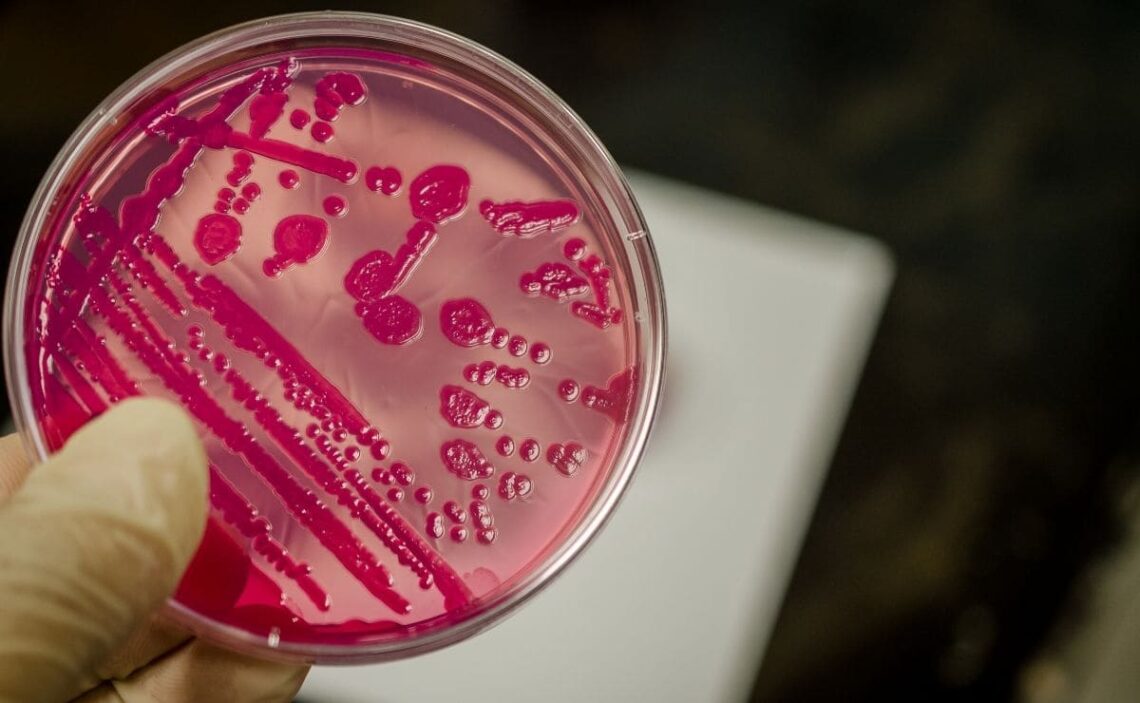

El riesgo de infección por el consumo de alimentos en mal estado es siempre una posibilidad a la hora de elegir nuestra dieta. En este caso vamos a hablar de la salmonelosis, una de las infecciones intestinales más comunes y la cual puede afectar sobre todo a bebés y a niños. Aunque nadie está exento de este riesgo.
La salmonella es una bacteria presente en el ambiente que puede perjudica el buen estado de alimentos y el agua. En un primer momento esto no tiene por qué percibirse ante nuestros ojos, aunque siempre debemos mantener la precaución de no ingerir productos que tengan mal aspecto.
Sin embargo, la salmonella puede estar presente en muchos alimentos que por una mala actividad en el proceso de elaboración y conservación pueden haberse contaminado. Así que realmente nadie está libre de sufrir salmonelosis alguna vez en la vida.
Uno de los factores de riesgo más comunes para contagiarnos con esta sustancia es viajar a ciertos países en vías de desarrollo cuyas medidas de higiene no sean demasiado estrictas. Por lo que si eres amante de este tipo de viajes ten mucho cuidado de no consumir alimentos que sepas que están en perfecto estado.
¿Cómo nos afecta la salmonella y cómo nos podemos contagiar?
Como hemos señalado anteriormente, la salmonella es una bacteria que afecta mayoritariamente a la salud intestinal. Por lo que vamos a perjudicar tanto el intestino como el sistema digestivo y el sistema inmunitario.

En este sentido, uno de los síntomas más comunes de la salmonella es la diarrea moderada o grave, dolor abdominal, fiebre, escalofríos o un deterioro de las capacidades cognitivas.
Según la web dedicada a informar acerca de la salud Mayo Clinic: «La infección por salmonella suele ser producto de comer carnes, aves, huevos o productos a base de huevo que estén crudos o poco cocidos. El período de incubación oscila entre varias horas y dos días».
Si bien es cierto que en mayor medida puede afectar a bebés y a niños con un sistema inmunitario más débil, lo cierto es que todo el mundo puede sufrir este tipo de infección a lo largo de su vida. Sobre todo si viaja a países donde las medidas de higiene alimentarias no están del todo claras, o si tiene en casa algún reptil o ave.
Y es que estos dos animales son los más propensos a contagiarse con esta bacteria y a traspasarla a los humanos. Así, el contagio también puede producirse entre personas que sufran esta infección en su organismo.
¿Es el huevo crudo un alimento peligroso para contraer salmonella?
Sin duda uno de los productos que más riesgo va a producir en nuestro cuerpo para contraer la salmonella es el huevo crudo. Y es que debemos tener mucho cuidado con este alimento, ya que realmente va a infectarnos de salmonella rápidamente si está infectado.
Si bien es cierto que en el mercado actual existen unas medidas de higiene y prevención de infecciones muy estricta, todavía no estamos totalmente libres de contraer esta enfermedad. Así como de consumir un huevo que realmente no haya pasado satisfactoriamente estos controles.
Por esta razón, es muy importante que cocines los huevos y evites comerlos crudos. Ya que calentándolos y cocinándolos vamos a conseguir eliminar cualquier tipo de bacteria que tengan en su composición. Como ocurre con la salmonella.